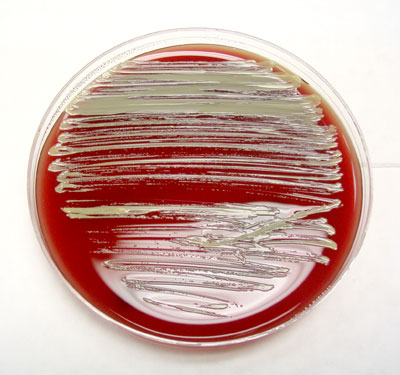

Hello hello,
I hope you are doing well this holiday season and are looking forward to a fresh start in the new year. What follows is an article about Sampling in Hospitals by Dr. Harriet Burge and about the bacterium Micrococcus by Subramani Thiagarajan. I hope you'll find them interesting and helpful.
With best wishes,
Dave Gallup
Sampling in Hospitals
By Dr. Harriet Burge
As with any investigation, the mantra to remember is, as the physicians say, "Do no harm." Harm is more easily done in a hospital than in many other environments. Even organisms that would be innocuous for most people may find a suitable host among hospital patients. Thus, when any kind of remediation is to be done, barriers are especially important, clearance requirements must be rigorous, and care should be taken not to introduce organisms from the investigators skin or clothing into the space. For most hospital sampling you are trying to prove that no contamination exists, i.e., you are trying to prove the negative case. This means that many samples will be required to increase the probability that the sampled area is free from harmful organisms.
The Centers for Disease Control (CDC) does not recommend sampling in hospitals except for monitoring of some pieces of equipment that tend to become colonized with bacteria. Note that the US Pharmacopeia General Chapter 797 (USP 797) does require routine air monitoring of sterile compounding areas, e.g., areas where IV solutions are prepared). However, most hospitals do very limited air monitoring, if any. This is, in part, because human-source pathogens would not be captured in air samples, not because they won't grow in culture, but because they are rarely present and then only transiently. Environmental organisms could be detected with a good monitoring program (see below). However, because monitoring is not often done, it is especially important that maintenance be rigorously pursued. In fact, one job of the hospital infection person might be to visually monitor the maintenance of problem areas. Routine inspection of the air handling system, especially in sensitive places such as operating rooms, and rooms housing especially ill patients, could prevent contamination that could lead to opportunistic infections. Because hospital infection control personnel tend to be microbiologists (for obvious reasons), hiring professionals would probably be the best approach for these inspections. Likewise, routine surveillance for water damage (leaks, floods, excess water used in cleaning, dripping pipes, etc.) could allow remediation before mold growth happens.
I believe that air monitoring can be useful in hospitals to detect early development of fungal growth in hidden areas. Even a monthly protocol that covered operating rooms and areas of the hospital with immunocompromised patients could, if properly done, detect early signs of problems. The use of both spore traps and volumetric cultural sampling is appropriate. Spore traps would identify unusual organisms, and culture is very sensitive and can be directed toward known pathogens such as Aspergillus fumigatus. Duplicate samples are essential and more is better since you are trying to prove the negative case. For the spore traps, the laboratory should be instructed that Aspergillus fumigatus spores are of special interest. These are very tiny, and easily lost in debris. Although they cannot be definitively identified on spore traps, spores that fit their morphology can be noted and counted separately. If present, then cultural sampling may (or may not) confirm the identification. For culture, malt extract agar should be used, and the samples incubated at 37°C, or even 45°C if Aspergillus fumigatus is of primary concern. A. fumigatus will appear on plates very quickly (within a day or so), so that presence/absence data can be obtained quickly. For quantitative results, the usual 5-7 day incubation times should be used to be sure that slower growing strains have not been missed.

Aspergillus spores
Copyright © 2006 Environmental Microbiology Laboratory, Inc.
In the "State of the Science on Molds and Human Health," which is a statement from the chief of the CDC in July 2002, it is stated that "Fungi account for 9% of nosocomial infections." Because fungi are commonly elevated during remediation efforts, I would monitor for airborne fungi directly outside of containment, and, at least initially, in sensitive areas such as transplant wards. There are several reports in the literature of construction or remediation-related outbreaks of nosocomial (hospital source) fungal infections. Airlocks are especially important if entries to containment lead into hospital corridors. Spores that have settled onto clothing, skin and hair are shed as people move. Hopefully, most of these would be left inside the negative pressure air lock along with some kind of disposable outer garment.
Clearance sampling presents the usual problems: should one sample inside containment with the scrubbers running, without the scrubbers, after containment has been removed? For hospitals, I would do all three, using both spore traps and volumetric culture. The spore traps can be read quickly, so that the containment samples can be cleared on one day and, if they pass, the containment can be removed and the remediated space re-sampled.
Finally, as always, hypotheses should be formed in advance (on paper) and sampling strategies developed to ensure that resulting data is interpretable.
Reference:
CDC: "State of the Science on Molds and
Human Health" (PDF)
Microorganism of the Month: Micrococcus
By Subramani Thiagarajan
Microcoocus is a gram-positive, aerobic bacterium that is a member of the Micrococcaceae family. It is commonly isolated from human skin, animal and dairy products, and grows well in environments with little water or high salt concentrations. Micrococcus is not considered pathogen organism for healthy people. Rarely, it may also be associated with infections in the blood (sepsis), cause of pneumonia and endocarditis - an infection of the lining of the heart, especially in patients with weakened immune systems (Souhami et al., 1979 and Wharton et al., 1986).
Micrococcus cells are about 0.5 to 3.5 µm in diameter and usually arranged in tetrads or irregular clusters. Cells may produce pigment, and colonies in broth and on nutrient agar are then red or yellow (Figure 1).
Figure 1: Micrococcus yellow pigmentation on nutrient agar.
Copyright © 2006 Environmental Microbiology Laboratory, Inc.
Common Micrococcus species are M. luteus, M. roseus, M. varians, M. denitrificans, M. freudenreichii and M. colpogenes. Some species are found in air (M. luteus and M. roseus), in soil (M. denitrificans), in marine waters (M. colpogenes), and on the skin or in skin glands or skin-gland secretions of vertebrates (M. flavus). Those species found in milk, such as M. luteus, M. varians, and M. freudenreichii, are sometimes referred to as milk micrococci and can result in spoilage of milk products.
Micrococcus has the ability to utilize a wide range of unusual substrates, such as pyridine, herbicides, chlorinated biphenyls, and oil. They are likely involved in detoxification or biodegradation of many other environmental pollutants (Doddamani and Ninnekar, 2001). Micrococcus luteus degrades the compounds in sweat into ones producing unpleasant odors. Micrococcus luteus has been associated with spoilage of fish products.
Micrococcus in Indoor Environments
Micrococcus and Staphylococcus are common in indoor environments. Both are shed from human skin, and are found in areas of high occupant density and/or inadequate ventilation. Correlations between high levels of Micrococcus bacteria and poor ventilation levels have been noted.
Currently there are no established guidelines or standards for interpreting bacterial data in the indoor environment, and any interpretation always must be related to a specific hypothesis. Human source bacteria may be present in high concentrations when any human activity is occurring in the space. Generally, indoor bacterial populations should not be dominated by gram-negative bacteria. If they are, a source should be sought.
References:
1. Madigan, Michael, Martinko, John. 2005. Brock Biology of Microorganisms, 11th ed., Prentice Hall. ISBN 0-13-144329-1.
2. Wharton M, Rice JR, McCallum R, Gallis HA: Septic arthritis due to Micrococcus luteus. J Rheumatol 1986, 13:659-660.
3. Souhami L, Feld R, TuVnell PG, Fellner T. 1979. Micrococcus luteus pneumonia: a case report and review of the literature. Med Pediatr Oncol, 7:309-314.
4. Doddamani, HP and HZ Ninnekar. 2001. Biodegradation of carbaryl by a Micrococcus species. Curr Microbiol.. 43(1):69-73.